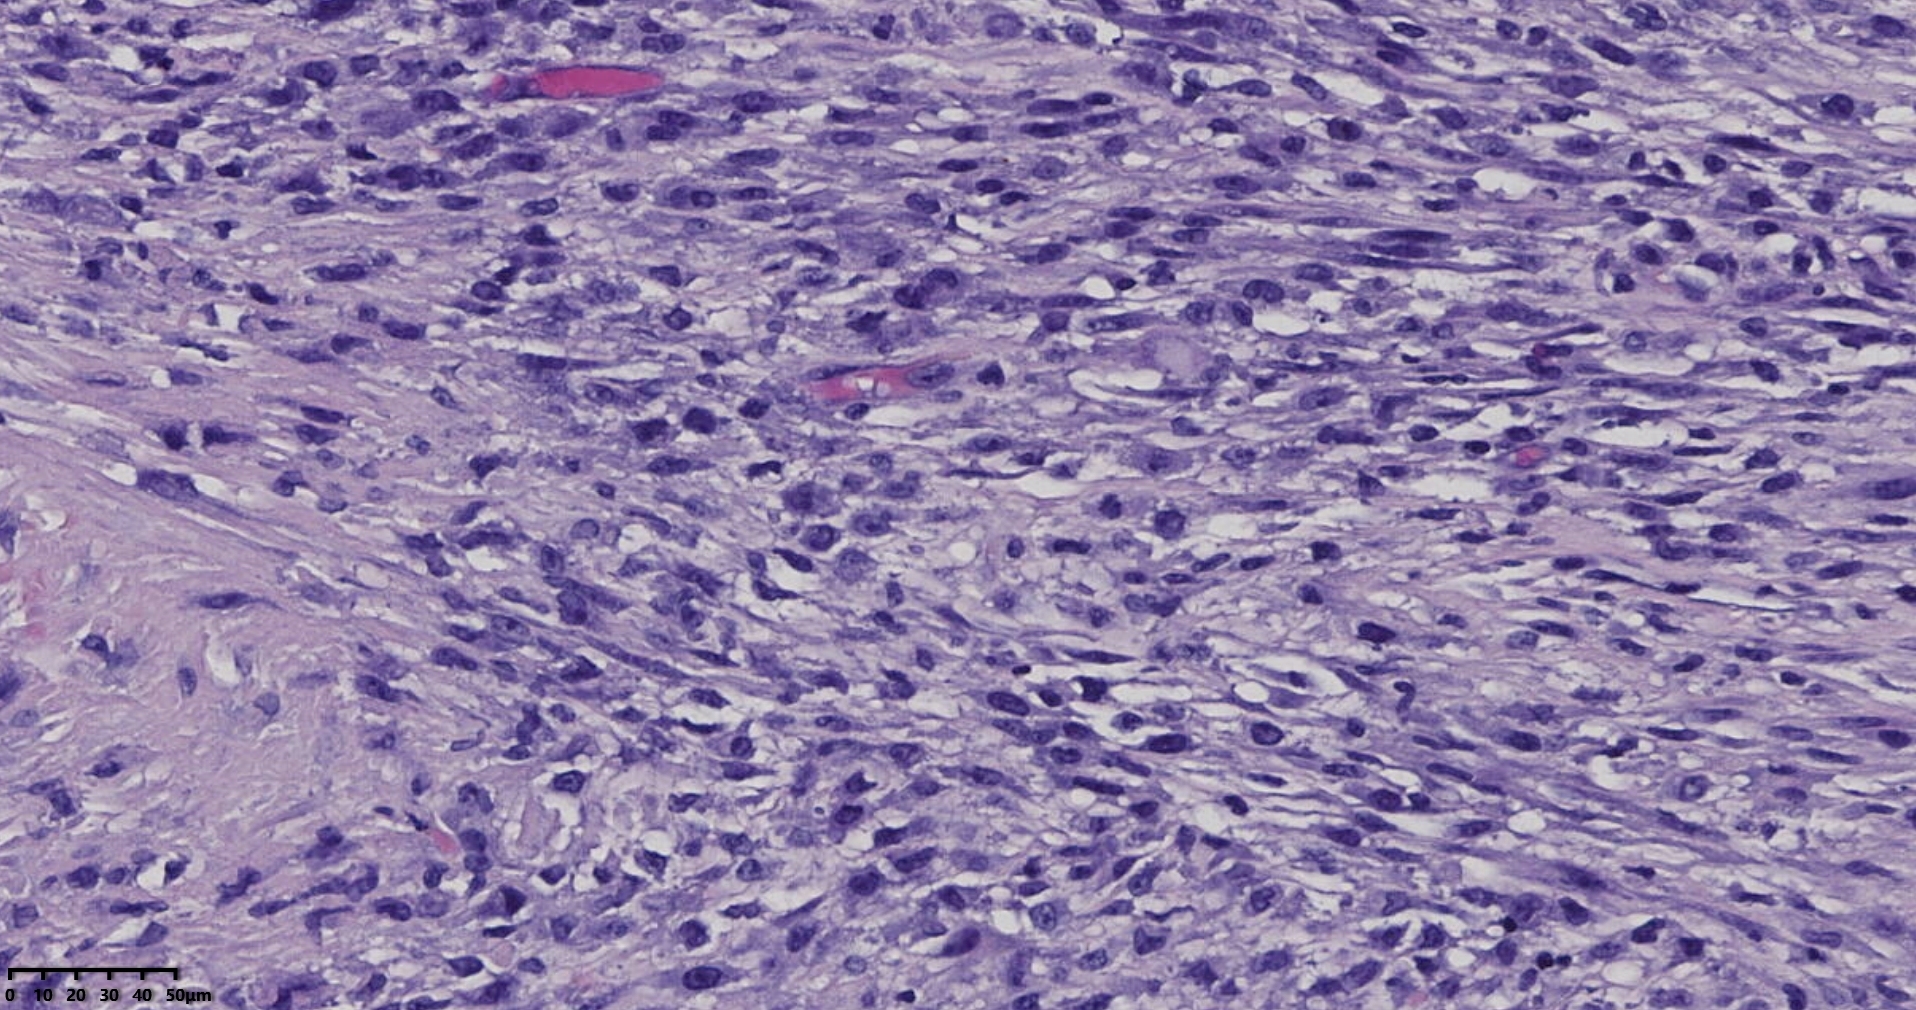
子宫多发性平滑肌瘤伴肉瘤

我的博文
子宫多发性平滑肌瘤伴肉瘤?
2025-12-19 15:13
阅读(43)
评论(0)
分类:女性生殖系统
女、43岁,子宫多发性平滑肌瘤剔除。255683
送检灰白肿物十余个,直径多在2-3厘米,切面均为灰白、实性,质地韧,其中一个大肿物,直径约7厘米,切片灰白灰红,质地韧当时取材时印象还是平滑肌瘤,伴变性,不考虑肉瘤,因为形态规整,质地韧,不脆,切面灰白,不是灰黄。
镜下所见小肿物无特殊,大肿物瘤细胞密集,中心区有变性、坏死,瘤细胞核有异型性。大肿物补充取材,发现,部分区域切面灰黄,这个区域,瘤细胞更密集,异型性更显著。肿物边缘有薄层正常平滑肌组织被覆,靠近边缘瘤细胞最密集,局部瘤组织内小血管较丰富。
会诊:考虑平滑肌肉瘤。
北医三院会诊:子宫平滑肌瘤伴红色变性可能性大,建议加做免疫组化及NGS检测进一步明确诊断。

本文允许在互联网范围内转载,使用时请注明作者姓名、作品名称及作品来源。
上一篇:肝细胞肝癌?
下一篇:这个甲状腺肿瘤怎么看?
我要评论
共0条评论